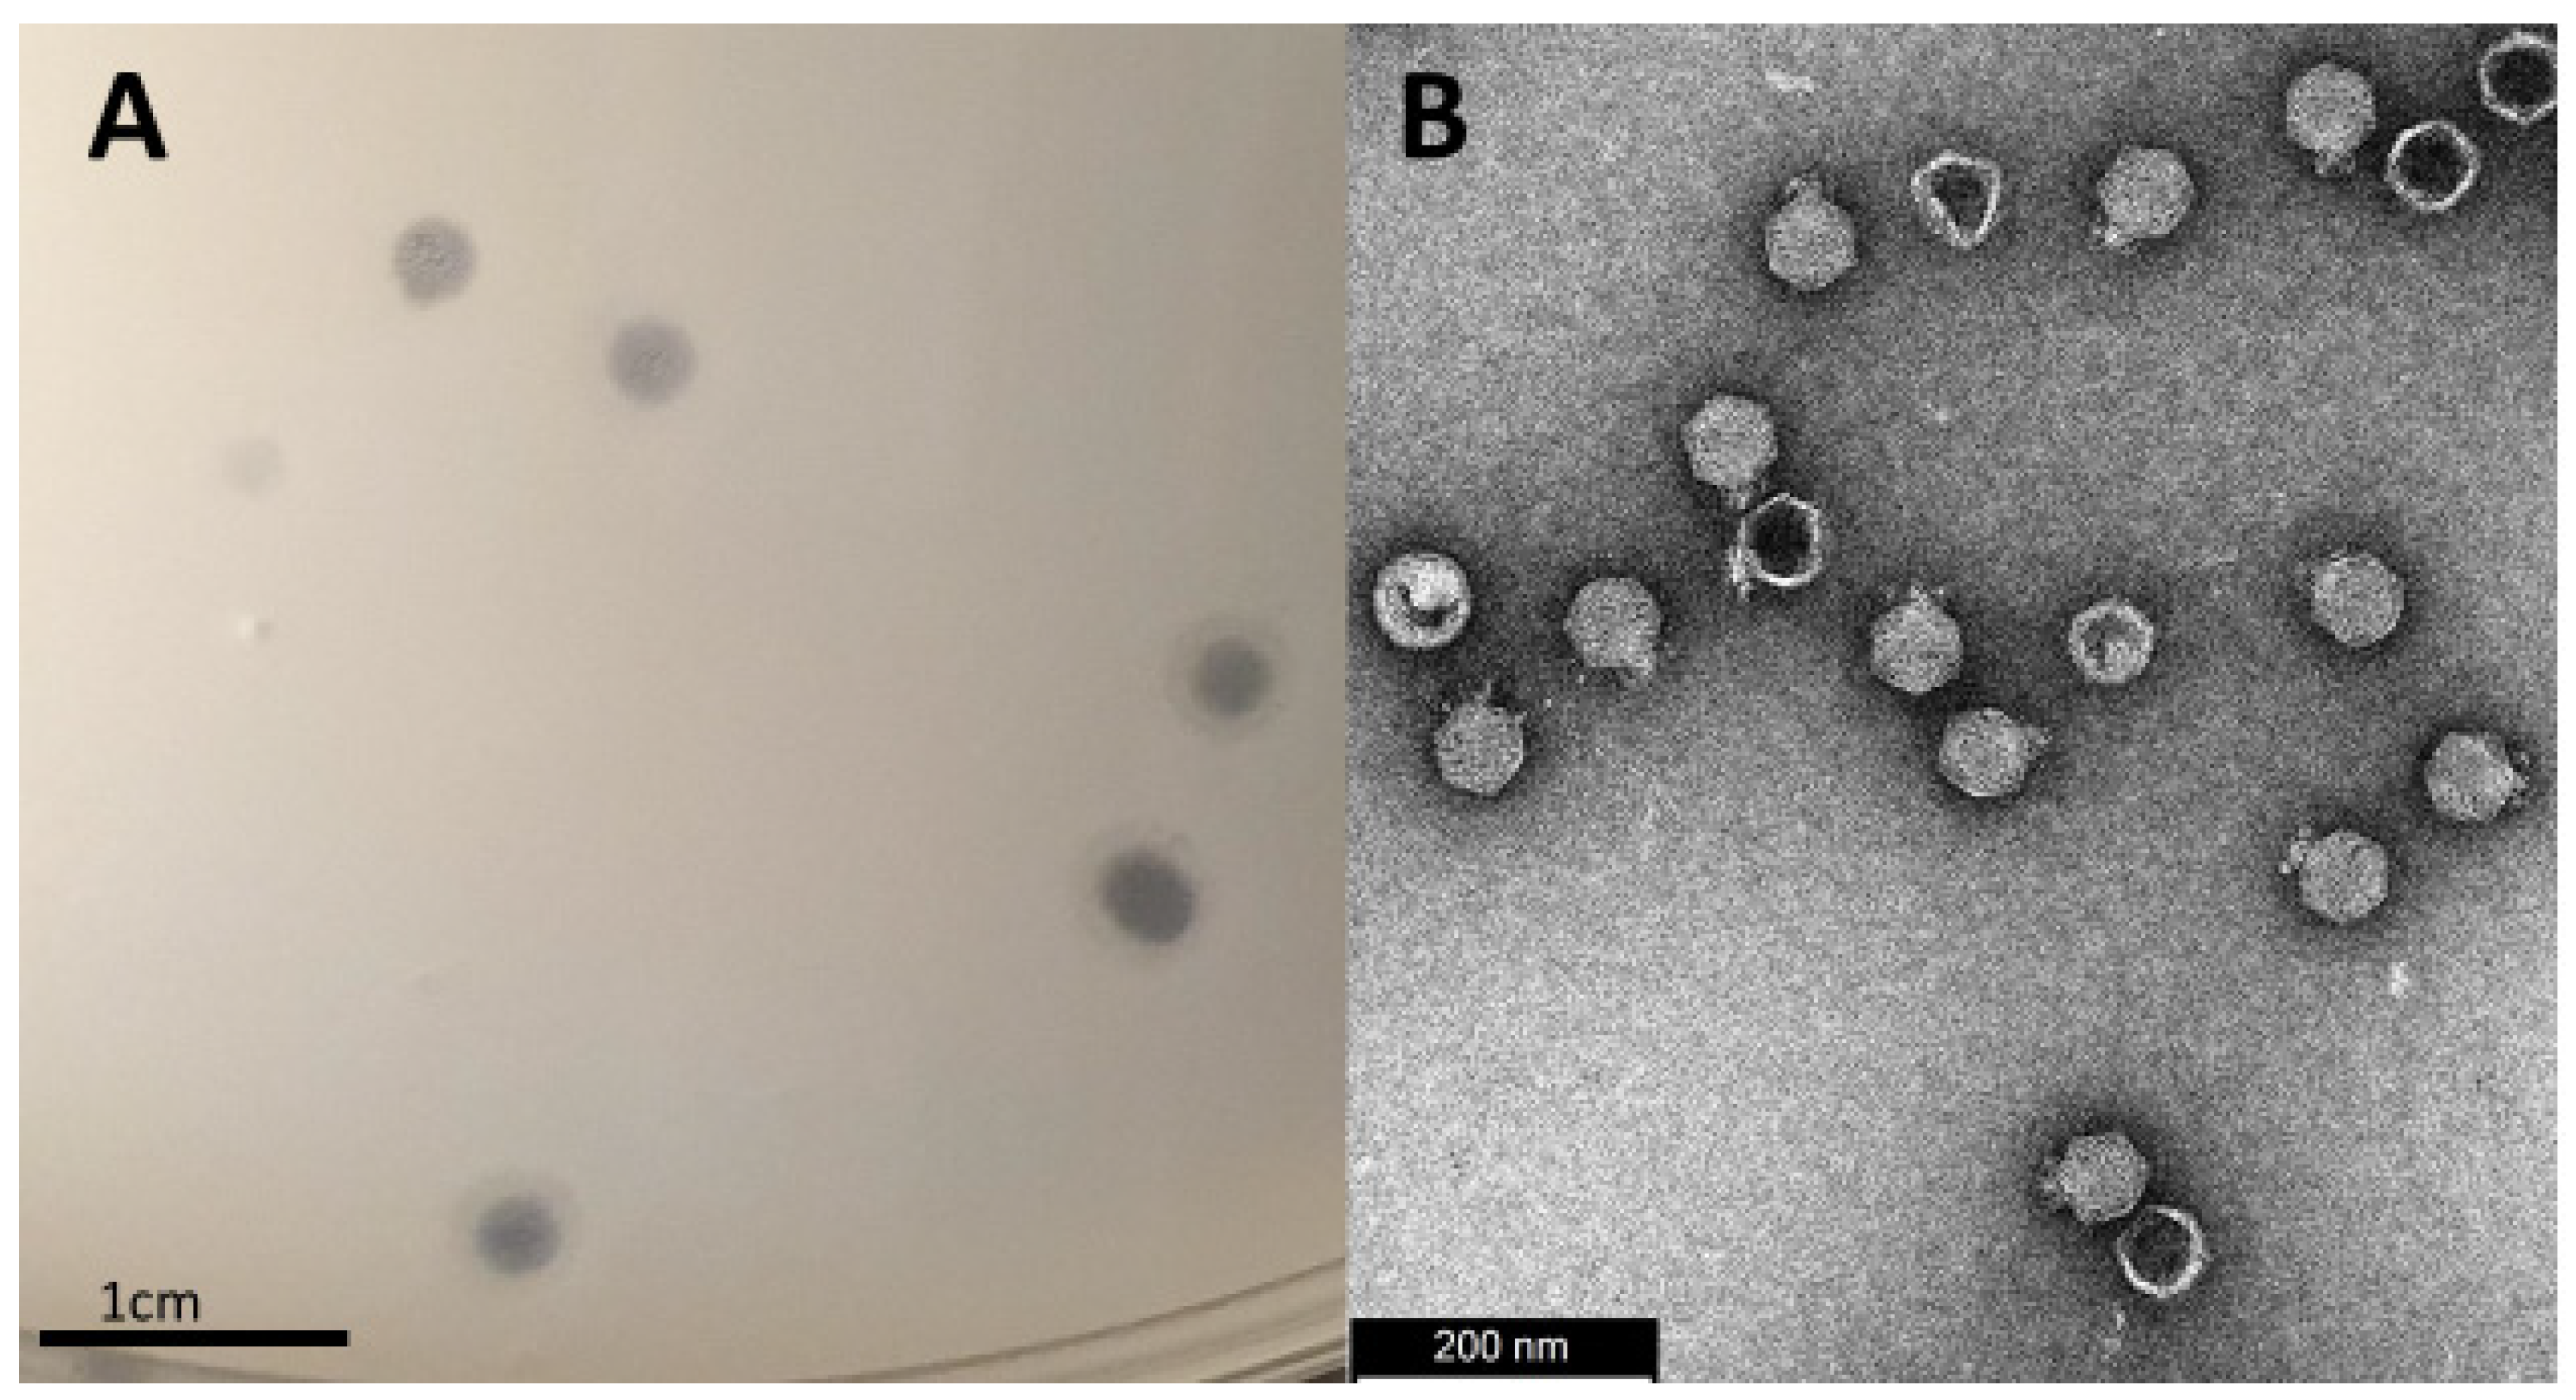
Viruses 14 01309 g001

Isolation and Characterization of Lytic Proteus Virus 309
Abstract
:1. Introduction
2. Materials and Methods
2.1. Bacterial Strains, Media, and Culturing Conditions
2.2. Phage Isolation and Purification
2.3. Phage Concentration
2.4. Transmission Electron Microscopy (TEM)
2.5. Extraction of Phage DNA
2.6. Sequencing of Phage Genome
2.7. Genome Annotation and Analysis
2.8. Host Specificity Determination
2.9. Multiplicity of Infection (MOI) and One-Step Growth Curve Determination
2.10. Bacterial Lysis Assay and Phage Resistance
2.11. Temperature and pH Stability
2.12. Statistical Analysis
3. Results and Discussion
3.1. Isolation, Morphology and Host-Range Characterization
3.2. Physiological Characterization
3.3. Genome Characterization
3.4. Additional Features
4. Conclusions
Supplementary Materials
Author Contributions
Funding
Institutional Review Board Statement
Informed Consent Statement
Data Availability Statement
Acknowledgments
Conflicts of Interest
References
- Armbruster, C.E.; Hodges, S.A.; Mobley, H.L. Initiation of swarming motility by Proteus mirabilis occurs in response to specific cues present in urine and requires excess l-glutamine. J. Bacteriol. 2013, 195, 1305–1319. [Google Scholar] [CrossRef] [PubMed] [Green Version]
- Pearson, M.M.; Sebaihia, M.; Churcher, C.; Quail, M.A.; Seshasayee, A.S.; Luscombe, N.M.; Abdellah, Z.; Arrosmith, C.; Atkin, B.; Chillingworth, T.; et al. Complete genome sequence of uropathogenic Proteus mirabilis, a master of both adherence and motility. J. Bacteriol. 2008, 190, 4027–4037. [Google Scholar] [CrossRef] [PubMed] [Green Version]
- Jansen, A.M.; Lockatell, V.; Johnson, D.E.; Mobley, H.L.T. Mannose-resistant Proteus-like fimbriae are produced by most Proteus mirabilis strains infecting the urinary tract, dictate the in vivo localization of bacteria, and contribute to biofilm formation. Infect. Immun. 2004, 72, 7294–7305. [Google Scholar] [CrossRef] [PubMed] [Green Version]
- Rocha, S.P.D.; Pelayo, J.S.; Elias, W.P. Fimbriae of uropathogenic Proteus mirabilis. FEMS Microbiol. Immunol. 2007, 51, 1–7. [Google Scholar] [CrossRef] [Green Version]
- Armbruster, C.E.; Mobley, H.L.T.; Pearson, M.M. Pathogenesis of Proteus mirabilis infection. EcoSal Plus. 2018, 8. [Google Scholar] [CrossRef] [Green Version]
- Dumanski, A.J.; Hedelin, H.; Edin-Liljegren, A.; Beauchemin, D.; McLean, R.J.C. Unique ability of the Proteus mirabilis capsule to enhance mineral growth in infectious urinary calculi. Infect. Immun. 1994, 62, 2998. [Google Scholar] [CrossRef] [Green Version]
- Czerwonka, G.; Guzy, A.; Kałuża, K.; Grosicka, M.; Dańczuk, M.; Lechowicz, Ł.; Gmiter, D.; Kowalczyk, P.; Kaca, W. The role of Proteus mirabilis cell wall features in biofilm formation. Arch. Microbiol. 2016, 198, 877. [Google Scholar] [CrossRef] [Green Version]
- Visalli, M.A.; Murphy, E.; Projan, S.J.; Bradford, P.A. AcrAB multidrug efflux pump is associated with reduced levels of susceptibility to tigecycline (GAR-936) in Proteus mirabilis. Antimicrob. Agents Chemother. 2003, 47, 665. [Google Scholar] [CrossRef] [Green Version]
- Murray, B.O.; Flores, C.; Williams, C.; Flusberg, D.A.; Marr, E.E.; Kwiatkowska, K.M.; Charest, J.L.; Isenberg, B.C.; Rohn, J.L. Recurrent urinary tract infection: A mystery in search of better model systems. Front. Cell Infect. Microbiol. 2021, 11, 440. [Google Scholar] [CrossRef]
- Jacobsen, S.M.; Stickler, D.J.; Mobley, H.L.T.; Shirtliff, M.E. Complicated catheter-associated urinary tract infections due to Escherichia coli and Proteus mirabilis. Clin. Microbiol. Rev. 2008, 21, 26–59. [Google Scholar] [CrossRef] [Green Version]
- Jarvis, W. Selected aspects of the socioeconomic impact of nosocomial infections: Morbidity, mortality, cost, and prevention. Infect. Control Hosp. Epidemiol. 1996, 17, 552–557. [Google Scholar] [CrossRef] [PubMed]
- Stock, I. Natural antibiotic susceptibility of Proteus spp., with special reference to P. mirabilis and P. penneri strains. J. Chemother. 2013, 15, 12–26. [Google Scholar] [CrossRef] [PubMed]
- Cunha, B.A.; Schoch, P.E.; Hage, J.R. Nitrofurantoin: Preferred empiric therapy for community-acquired lower urinary tract infections. Mayo Clin. Proc. 2011, 86, 1243. [Google Scholar] [CrossRef] [PubMed] [Green Version]
- Huang, C.W.; Chien, J.H.; Peng, R.Y.; Tsai, D.J.; Li, M.H.; Lee, H.M.; Lin, C.F.; Lee, M.C.; Liao, C.T. Molecular epidemiology of CTX-M-type extended-spectrum β-lactamase-producing Proteus mirabilis isolates in Taiwan. Int. J. Antimicrob. Agents. 2015, 45, 84–85. [Google Scholar] [CrossRef] [PubMed]
- Tibbetts, R.; Frye, J.G.; Marschall, J.; Warren, D.; Dunne, W. Detection of KPC-2 in a clinical isolate of Proteus mirabilis and first reported description of carbapenemase resistance caused by a KPC β-lactamase in P. mirabilis. J. Clin. Microbiol. 2008, 46, 3080. [Google Scholar] [CrossRef] [Green Version]
- Guillard, T.; Grillon, A.; de Champs, C.; Cartier, C.; Madoux, J.; Berçot, B.; Lebreil, A.-L.; Lozniewski, A.; Riahi, J.; Vernet-Garnier, V.; et al. Mobile insertion cassette elements found in small non-transmissible plasmids in Proteeae may explain qnrD mobilization. PLoS ONE 2014, 9, e87801. [Google Scholar] [CrossRef]
- Girlich, D.; Bonnin, R.A.; Dortet, L.; Naas, T. Genetics of acquired antibiotic resistance genes in Proteus spp. Front. Microbiol. 2020, 11, 256. [Google Scholar] [CrossRef] [Green Version]
- JAMA. Commercial aspects of bacteriophage therapy. J. Am. Med. Assoc. 1933, 100, 1603–1604. [Google Scholar] [CrossRef]
- Wright, A.; Hawkins, C.H.; Änggård, E.E.; Harper, D.R. A controlled clinical trial of a therapeutic bacteriophage preparation in chronic otitis due to antibiotic-resistant Pseudomonas aeruginosa; a preliminary report of efficacy. Clin. Otolaryngol. 2009, 34, 349–357. [Google Scholar] [CrossRef]
- Altamirano, F.L.G.; Barr, J.J. Phage therapy in the postantibiotic era. Clin. Microbiol. Rev. 2019, 32, e00066-18. [Google Scholar] [CrossRef] [Green Version]
- Abedon, S.T. Phage-antibiotic combination treatments: Antagonistic impacts of antibiotics on the pharmacodynamics of phage therapy? Antibiotics 2019, 8, 182. [Google Scholar] [CrossRef] [PubMed] [Green Version]
- Easwaran, M.; de Zoysa, M.; Shin, H.-J. Application of phage therapy: Synergistic effect of phage EcSw (ΦEcSw) and antibiotic combination towards antibiotic-resistant Escherichia coli. Transbound Emerg. Dis. 2020, 67, 2809–2817. [Google Scholar] [CrossRef] [PubMed]
- Kamal, F.; Dennis, J.J. Burkholderia cepacia complex Phage-Antibiotic Synergy (PAS): Antibiotics stimulate lytic phage activity. Appl. Environ. Microbiol. 2015, 81, 1132–1138. [Google Scholar] [CrossRef] [Green Version]
- Dickey, J.; Perrot, V. Adjunct phage treatment enhances the effectiveness of low antibiotic concentration against Staphylococcus aureus biofilms in vitro. PLoS ONE 2019, 14, e0209390. [Google Scholar] [CrossRef] [PubMed] [Green Version]
- Wang, Z.; Cai, R.; Wang, G.; Guo, Z.; Liu, X.; Guan, Y.; Ji, Y.; Zhang, H.; Xi, H.; Zhao, R.; et al. Combination therapy of phage VB_KpnM_P-KP2 and gentamicin combats acute pneumonia caused by K47 serotype Klebsiella pneumoniae. Front. Microbiol. 2021, 12, 926. [Google Scholar] [CrossRef] [PubMed]
- Maciejewska, B.; Olszak, T.; Drulis-Kawa, Z. Applications of bacteriophages versus phage enzymes to combat and cure bacterial infections: An ambitious and also a realistic application? Appl. Microbiol. Biotechnol. 2018, 102, 2563–2581. [Google Scholar] [CrossRef] [Green Version]
- Danis-Wlodarczyk, K.; Olszak, T.; Arabski, M.; Wasik, S.; Majkowska-Skrobek, G.; Augustyniak, D.; Gula, G.; Briers, Y.; Jang, H.B.; Vandenheuvel, D.; et al. Characterization of the newly isolated lytic bacteriophages KTN6 and KT28 and their efficacy against Pseudomonas aeruginosa biofilm. PLoS ONE 2015, 10, e0127603. [Google Scholar] [CrossRef]
- Gomaa, S.; Serry, F.; Abdellatif, H.; Abbas, H. Elimination of multidrug-resistant Proteus mirabilis biofilms using bacteriophages. Arch. Virol. 2019, 164, 2265–2275. [Google Scholar] [CrossRef]
- Melo, L.D.R.; Veiga, P.; Cerca, N.; Kropinski, A.M.; Almeida, C.; Azeredo, J.; Sillankorva, S. Development of a phage cocktail to control Proteus mirabilis catheter-associated urinary tract infections. Front. Microbiol. 2016, 7, 1024. [Google Scholar] [CrossRef] [Green Version]
- Milo, S.; Hathaway, H.; Nzakizwanayo, J.; Alves, D.R.; Esteban, P.P.; Jones, B.V.; Jenkins, A.T.A. Prevention of encrustation and blockage of urinary catheters by Proteus mirabilis via pH-triggered release of bacteriophage. J. Mater. Chem. B. 2017, 5, 5403–5411. [Google Scholar] [CrossRef] [Green Version]
- Pelzek, A.J.; Schuch, R.; Schmitz, J.E.; Fischetti, V.A. Isolation of bacteriophages from environmental sources, and creation and functional screening of phage dna libraries. Curr. Proto. Essent. Lab. Technol. 2013, 7, 13.3.1–13.3.35. [Google Scholar] [CrossRef]
- Anderson, B.; Rashid, M.H.; Carter, C.; Pasternack, G.; Rajanna, C.; Revazishvili, T.; Dean, T.; Senecal, A.; Sulakvelidze, A. Enumeration of bacteriophage particles: Comparative analysis of the traditional plaque assay and real-time qPCR- and nanosight-based assays. Bacteriophage 2011, 1, 86. [Google Scholar] [CrossRef] [PubMed] [Green Version]
- Cross, T.; Schoff, C.; Chudoff, D.; Graves, L.; Broomell, H.; Terry, K.; Farina, J.; Correa, A.; Shade, D.; Dunbar, D. An optimized enrichment technique for the isolation of Arthrobacter bacteriophage species from soil sample isolates. J. Vis. Exp. 2015, 98, 52781. [Google Scholar] [CrossRef] [PubMed] [Green Version]
- Yamamoto, K.R.; Alberts, B.M.; Benzinger, R.; Lawhorne, L.; Treiber, G. Rapid bacteriophage sedimentation in the presence of polyethylene glycol and its application to large-scale virus purification. Virology 1970, 40, 734–744. [Google Scholar] [CrossRef]
- Göller, P.C.; Haro-Moreno, J.M.; Rodriguez-Valera, F.; Loessner, M.J.; Gómez-Sanz, E. Uncovering a hidden diversity: Optimized protocols for the extraction of dsDNA bacteriophages from soil. Microbiome 2020, 8, 17. [Google Scholar] [CrossRef] [Green Version]
- Zhou, C.L.E.; Kimbrel, J.; Edwards, R.; McNair, K.; Souza, B.A.; Malfatti, S. MultiPhATE2: Code for functional annotation and comparison of phage genomes. G3 Genes Genom. Genet. 2021, 11, jkab074. [Google Scholar] [CrossRef]
- Moraru, C.; Varsani, A.; Kropinski, A.M. VIRIDIC—A novel tool to calculate the intergenomic similarities of prokaryote-infecting viruses. Viruses 2020, 12, 1268. [Google Scholar] [CrossRef]
- Gilchrist, C.L.M.; Chooi, Y.H. Clinker & Clustermap.Js: Automatic generation of gene cluster comparison figures. Bioinform. 2021, 37, 2473–2475. [Google Scholar] [CrossRef]
- Moraru, C. VirClust–A tool for hierarchical clustering, core gene detection and annotation of (prokaryotic) viruses. BioRxiv 2021, BioRxiv:2021.06.14.448304. [Google Scholar] [CrossRef]
- Hockenberry, A.J.; Wilke, C.O. Bacphlip: Predicting bacteriophage lifestyle from conserved protein domains. Peer J. 2021, 9, e11396. [Google Scholar] [CrossRef]
- Yin, Y.; Ni, P.; Liu, D.; Yang, S.; Almeida, A.; Guo, Q.; Zhang, Z.; Deng, L.; Wang, D. Bacteriophage potential against Vibrio parahaemolyticus biofilms. Food Control 2019, 98, 156–163. [Google Scholar] [CrossRef]
- Yen, M.; Cairns, L.S.; Camilli, A. A cocktail of three virulent bacteriophages prevents Vibrio cholerae infection in animal models. Nat. Commun. 2017, 8, 14187. [Google Scholar] [CrossRef] [PubMed] [Green Version]
- Yang, M.; Liang, Y.; Huang, S.; Zhang, J.; Wang, J.; Chen, H.; Ye, Y.; Gao, X.; Wu, Q.; Tan, Z. Isolation and characterization of the novel phages VB_VpS_BA3 and VB_VpS_CA8 for lysing Vibrio parahaemolyticus. Front. Microbiol. 2020, 11, 259. [Google Scholar] [CrossRef] [PubMed]
- Morozova, V.; Kozlova, Y.; Shedko, E.; Babkin, I.; Kurilshikov, A.; Bokovaya, O.; Bardashova, A.; Yunusova, A.; Tikunov, A.; Tupikin, A.; et al. Isolation and characterization of a group of new Proteus bacteriophages. Arch. Virol. 2018, 163, 2189–2197. [Google Scholar] [CrossRef]
- Alves, D.R.; Nzakizwanayo, J.; Dedi, C.; Olympiou, C.; Hanin, A.; Kot, W.; Hansen, L.; Lametsch, R.; Gahan, C.G.M.; Schellenberger, P.; et al. Genomic and ecogenomic characterization of Proteus mirabilis bacteriophages. Front. Microbiol. 2019, 10, 1783. [Google Scholar] [CrossRef] [Green Version]
- Yazdi, M.; Bouzari, M.; Ghaemi, E.A. Isolation and characterization of a lytic bacteriophage (VB_PmiS-TH) and its application in combination with ampicillin against planktonic and biofilm forms of Proteus mirabilis isolated from urinary tract infection. Microb. Physiol. 2018, 28, 37–46. [Google Scholar] [CrossRef]
- Corban, J.E.; Ramsey, J. Characterization and complete genome sequence of Privateer, a highly prolate Proteus mirabilis podophage. Peer J. 2021, 9, e10645. [Google Scholar] [CrossRef]
- Pirnay, J.P. Phage therapy in the year 2035. Front. Microbiol. 2020, 11, 1171. [Google Scholar] [CrossRef]
- Pires, D.P.; Monteiro, R.; Mil-Homens, D.; Fialho, A.; Lu, T.K.; Azeredo, J. Designing P. aeruginosa synthetic phages with reduced genomes. Sci. Rep. 2021, 11, 2164. [Google Scholar] [CrossRef]
- Mangalea, M.R.; Duerkop, B.A. Fitness trade-offs resulting from bacteriophage resistance potentiate synergistic antibacterial strategies. Infect. Immun. 2020, 88, e00926-19. [Google Scholar] [CrossRef] [Green Version]
- Seed, K.D.; Faruque, S.M.; Mekalanos, J.J.; Calderwood, S.B.; Qadri, F.; Camilli, A. Phase variable O antigen biosynthetic genes control expression of the major protective antigen and bacteriophage receptor in Vibrio cholerae O1. PLoS Pathog. 2012, 8, e1002917. [Google Scholar] [CrossRef] [PubMed] [Green Version]
- Lane, M.C.; Li, X.; Pearson, M.M.; Simms, A.N.; Mobley, H.L.T. Oxygen-limiting conditions enrich for fimbriate cells of uropathogenic Proteus mirabilis and Escherichia coli. J. Bacteriol. 2009, 191, 1382. [Google Scholar] [CrossRef] [PubMed] [Green Version]
- Labrie, S.J.; Samson, J.E.; Moineau, S. Bacteriophage resistance mechanisms. Nat. Rev. Microbiol. 2010, 8, 317–327. [Google Scholar] [CrossRef] [PubMed]
- Rice, C.J.; Kelly, S.A.; O’brien, S.C.; Melaugh, E.M.; Ganacias, J.C.B.; Chai, Z.H.; Gilmore, B.F.; Skvortsov, T. Novel phage-derived depolymerase with activity against Proteus mirabilis biofilms. Microorganisms 2021, 9, 2172. [Google Scholar] [CrossRef]
- Adriaenssens, E.M.; Sullivan, M.B.; Knezevic, P.; van Zyl, L.J.; Sarkar, B.L.; Dutilh, B.E.; Alfenas-Zerbini, P.; Łobocka, M.; Tong, Y.; Brister, J.R.; et al. Taxonomy of prokaryotic viruses: 2018-2019 update from the ICTV bacterial and archaeal viruses subcommittee. Arch. Virol. 2020, 165, 1253–1260. [Google Scholar] [CrossRef] [Green Version]
- Roberts, G.A.; Stephanou, A.S.; Kanwar, N.; Dawson, A.; Cooper, L.P.; Chen, K.; Nutley, M.; Cooper, A.; Blakely, G.W.; Dryden, D.T.F. Exploring the dna mimicry of the ocr protein of phage T7. Nucleic Acids Res. 2012, 40, 8129–8143. [Google Scholar] [CrossRef] [Green Version]
- Isaev, A.; Drobiazko, A.; Sierro, N.; Gordeeva, J.; Yosef, I.; Qimron, U.; Ivanov, N.V.; Severinov, K. Phage T7 DNA mimic protein ocr is a potent inhibitor of BREX defence. Nucleic Acids Res. 2020, 48, 5397–5406. [Google Scholar] [CrossRef]
- Murphy, J.; Mahony, J.; Ainsworth, S.; Nauta, A.; van Sinderen, D. Bacteriophage orphan DNA methyltransferases: Insights from their bacterial origin, function, and occurrence. Appl. Environ. Microbiol. 2013, 79, 7547–7555. [Google Scholar] [CrossRef] [Green Version]
- Abedon, S.T.; Herschler, T.D.; Stopar, D. Bacteriophage latent-period evolution as a response to resource availability. Appl. Environ. Microbiol. 2001, 67, 4233–4241. [Google Scholar] [CrossRef] [Green Version]
- Abedon, S.T. Look who’s talking: T-Even phage lysis inhibition, the granddaddy of virus-virus intercellular communication research. Viruses 2019, 11, 951. [Google Scholar] [CrossRef] [Green Version]
- Gil, F.; Catalão, M.J.; Moniz-Pereira, J.; Leandro, P.; McNeil, M.; Pimentel, M. The lytic cassette of mycobacteriophage Ms6 encodes an enzyme with lipolytic activity. Microbiology 2008, 154, 1364–1371. [Google Scholar] [CrossRef] [PubMed] [Green Version]
- Gigante, A.M.; Hampton, C.M.; Dillard, R.S.; Gil, F.; Catalão, M.J.; Moniz-Pereira, J.; Wright, E.R.; Pimentel, M. The Ms6 mycolyl-arabinogalactan esterase LysB is essential for an efficient mycobacteriophage-induced lysis. Viruses 2017, 9, 343. [Google Scholar] [CrossRef] [PubMed] [Green Version]
- Sychantha, D.; Brott, A.S.; Jones, C.S.; Clarke, A.J. Mechanistic pathways for peptidoglycan O-acetylation and de-O-acetylation. Front. Microbiol. 2018, 9, 2332. [Google Scholar] [CrossRef]
- Dupont, C.; Clarke, A.J. Dependence of lysozyme-catalysed solubilization of Proteus mirabilis peptidoglycan on the extent of O-acetylation. Eur. J. Biochem. 1991, 195, 763–769. [Google Scholar] [CrossRef] [PubMed]
- Christensen, H.M.; Oscarson, S.; Jensen, H.H. Common side reactions of the glycosyl donor in chemical glycosylation. Carbohydr. Res. 2015, 408, 51–95. [Google Scholar] [CrossRef]
- Morozova, V.; Kozlova, Y.; Shedko, E.; Kurilshikov, A.; Babkin, I.; Tupikin, A.; Yunusova, A.; Chernonosov, A.; Baykov, I.; Kondratov, I.; et al. Lytic bacteriophage PM16 specific for Proteus mirabilis: A novel member of the genus Phikmvvirus. Arch. Virol. 2016, 161, 2457–2472. [Google Scholar] [CrossRef]
- Beynon, L.M.; Dumanski, A.J.; McLean, R.J.C.; MacLean, L.L.; Richards, J.C.; Perry, M.B. Capsule structure of Proteus mirabilis (ATCC 49565). J. Bacteriol. 1992, 174, 2172–2177. [Google Scholar] [CrossRef] [Green Version]
- Fallah, M.S.; Mohebbi, A.; Yasaghi, M.; Ghaemi, E.A. CRISPR-Cas systems in Proteus mirabilis. Infect. Genet. Evol. 2021, 92, 104881. [Google Scholar] [CrossRef]

Publisher’s Note: MDPI stays neutral with regard to jurisdictional claims in published maps and institutional affiliations. |
© 2022 by the authors. Licensee MDPI, Basel, Switzerland. This article is an open access article distributed under the terms and conditions of the Creative Commons Attribution (CC BY) license (https://creativecommons.org/licenses/by/4.0/).
Share and Cite
Aaron, J.; van Zyl, L.J.; Dicks, L.M.T. Isolation and Characterization of Lytic Proteus Virus 309. Viruses 2022, 14, 1309. https://doi.org/10.3390/v14061309
Aaron J, van Zyl LJ, Dicks LMT. Isolation and Characterization of Lytic Proteus Virus 309. Viruses. 2022; 14(6):1309. https://doi.org/10.3390/v14061309
Chicago/Turabian StyleAaron, Joshua, Leonardo J. van Zyl, and Leon M. T. Dicks. 2022. "Isolation and Characterization of Lytic Proteus Virus 309" Viruses 14, no. 6: 1309. https://doi.org/10.3390/v14061309
APA StyleAaron, J., van Zyl, L. J., & Dicks, L. M. T. (2022). Isolation and Characterization of Lytic Proteus Virus 309. Viruses, 14(6), 1309. https://doi.org/10.3390/v14061309

